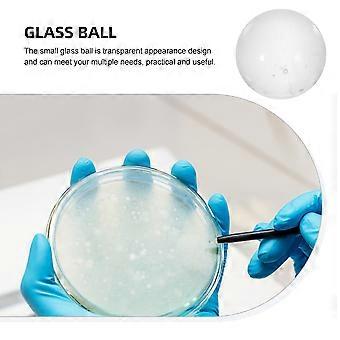
product image

Clear Solid Glass Ball 2000Pcs Mini Sphere for Laboratory
FREE Shipping

Clear Solid Glass Ball 2000Pcs Mini Sphere for Laboratory
- Brand: Unbranded
Clear Solid Glass Ball 2000Pcs Mini Sphere for Laboratory
- Brand: Unbranded
AED69.00
Save AED50.00 (42%)
RRP
14-Day Returns Policy
AED69.00
Save AED50.00 (42%)
RRP
14-Day Returns Policy
Payment methods:
Description
Clear Solid Glass Ball 2000Pcs Mini Sphere for Laboratory
- Brand: Unbranded
- Category: Beakers
- Fruugo ID: 457301951-963552778
- EAN: 3401307763259
Product Safety Information
Please see the product safety information specific to this product outlined below
The following information is provided by the independent third-party retailer selling this product.
Product Safety Labels

Delivery
Dispatched within 24 hours
-
STANDARD: FREE - Delivery between Thu 18 June 2026–Thu 25 June 2026 - FREE
Shipping from China.
Returns
We do our best to ensure that the products that you order are delivered to you in full and according to your specifications. However, should you receive an incomplete order, or items different from the ones you ordered, or there is some other reason why you are not satisfied with the order, you may return the order, or any products included in the order, and receive a full refund for the items.
Product Compliance Details
Please see the compliance information specific to this product outlined below.
The following information is provided by the independent third-party retailer selling this product.
Manufacturer
The following information outlines the contact details for the manufacturer of the relevant product sold on Fruugo.
- Shenzhen Woyingpei Trade Co., Ltd.
- Shenzhen Woyingpei Trade Co., Ltd.
- shen zhen shi nan shan qu yue hai jie dao ke ji yuan she qu ke zhi xi lu 1 hao ke yuan xi 23 dong bei 2101
- Shenzhen
- CN
- 518000
- [email protected]
- 19925352422
Responsible Person in the EU
The following information outlines the contact information for the responsible person in the EU. The responsible person is the designated economic operator based in the EU who is responsible for the compliance obligations relating to the relevant product sold into the European Union.
- EC REP SERVICES SL
- EC REP SERVICES SL
- Calle Gran Via 49, 7 Dch.
- Madrid
- ES
- 28013
- [email protected]
- 0034 910 5631 02